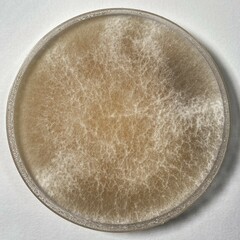
Phanerochaete concrescens
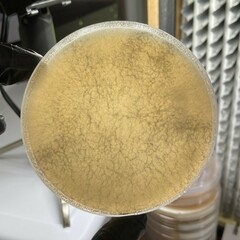
Phanerochaete concrescens
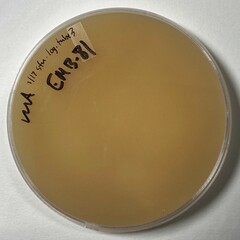
Phanerochaete concrescens

Phanerochaete concrescens: taxon details and analytics
- Domain
- Kingdom
- Fungi
- Phylum
- Basidiomycota
- Class
- Agaricomycetes
- Order
- Polyporales
- Family
- Phanerochaetaceae
- Genus
- Phanerochaete
- Species
- Phanerochaete concrescens
- Scientific Name
- Phanerochaete concrescens
Parent Taxon
Sibling Taxa
- Atheliachaete andina
- Phanerochaete affinis
- Phanerochaete arenata
- Phanerochaete areolata
- Phanerochaete arizonica
- Phanerochaete aurata
- Phanerochaete australis
- Phanerochaete australosanguinea
- Phanerochaete avellanea
- Phanerochaete burtii
- Phanerochaete cacaina
- Phanerochaete calotricha
- Phanerochaete carnosa
- Phanerochaete caucasica
- Phanerochaete citrinosanguinea
- Phanerochaete concrescens
- Phanerochaete cordylines
- Phanerochaete cremeo-ochracea
- Phanerochaete deflectens
- Phanerochaete galactites
- Phanerochaete inflata
- Phanerochaete jose-ferreirae
- Phanerochaete laevis
- Phanerochaete livescens
- Phanerochaete luteoaurantiaca
- Phanerochaete martelliana
- Phanerochaete monomitica
- Phanerochaete rhodella
- Phanerochaete sanguinea
- Phanerochaete sanguineocarnosa
- Phanerochaete sordida
- Phanerochaete tuberculata
- Phanerochaete velutina
- Phanerochaete xerophila